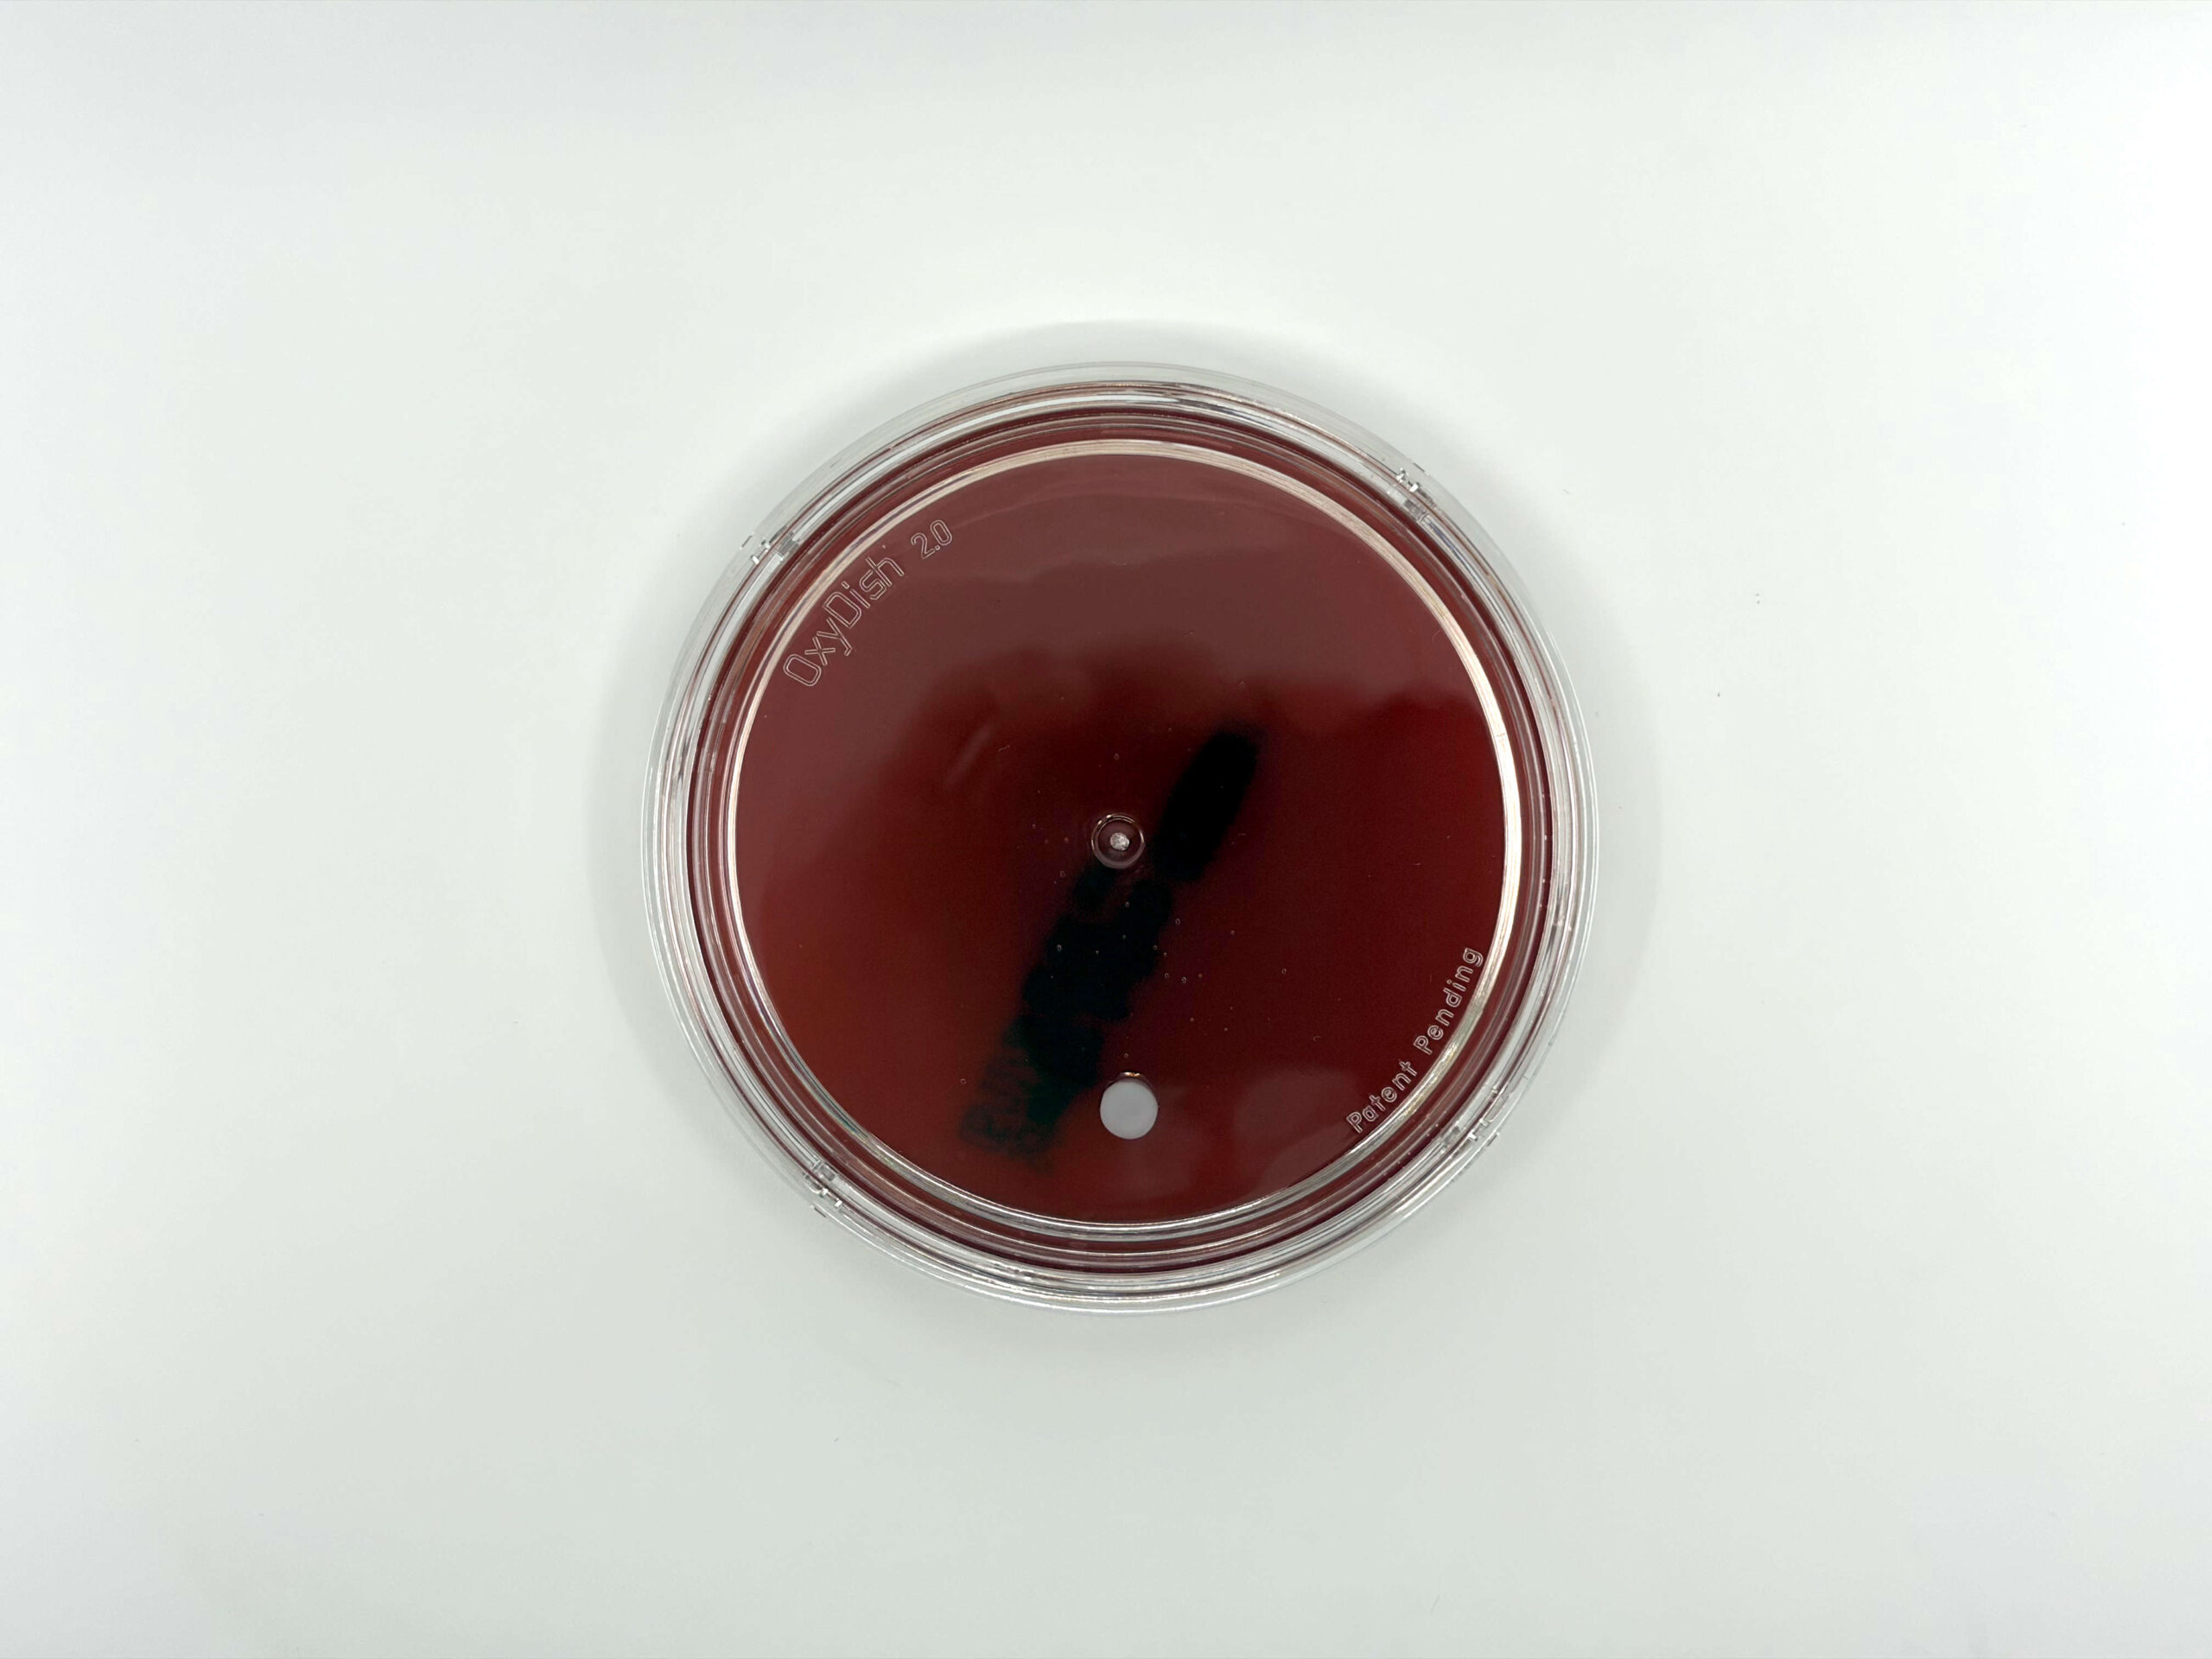
OxyPlate anaerobic culture plate with OxyDish seal and OxyBlue indicator showing anaerobic conditions

What is the Oxyrase® Enzyme System?
Sterile E. coli membrane fragments, about a tenth of a micron across, with their electron transport chains still intact. Add a substrate like lactate, and they start pulling dissolved oxygen out of solution, reducing it all the way to water. No radicals. No chemical residues. No special equipment. Four decades of published research across microbiology, microscopy, cryopreservation, and half a dozen other fields.
The short version: membrane fragments that breathe for your media
Take the cytoplasmic membrane of E. coli, lyse the cells, and sterilize what’s left. You end up with sub-micron vesicles, roughly 0.1 μm, that still carry a full set of functional respiratory enzymes. They’ll accept electrons from simple organic substrates and hand them off down the chain until cytochrome c oxidase drops them onto O₂. Four electrons per molecule. End product: water.
This isn’t a single purified enzyme. The whole respiratory chain is still embedded in the native phospholipid bilayer, arranged the same way it was in the living cell, just without the cell around it. Drop in 10–20 mM sodium DL-lactate as an electron donor, and oxygen scavenging starts immediately. At 37°C, 0.3 units will pull dissolved O₂ down to parts-per-billion in about four minutes.
What chemical reducers can’t do
Thioglycolate, L-cysteine, sodium sulfide: they all remove oxygen by reacting with it. Once the reagent is spent, it’s done. And along the way, each one generates byproducts (disulfides, elemental sulfur, H₂S) that can inhibit fastidious anaerobes, degrade fluorophores, or damage cells during cryopreservation. The Oxyrase enzyme system doesn’t work that way.
Catalytic, not consumed
A single enzyme molecule turns over thousands of O₂ molecules. As long as substrate is present, scavenging continues.
The only byproduct is water
Full four-electron reduction. No superoxide, no peroxide, no hydroxyl radicals. Just H₂O.
Goes after O₂ and nothing else
Cytochrome c oxidase has high specificity for molecular oxygen. It won’t interfere with other redox chemistry in your system.
Works the way cells do
Same electron transport mechanism found in every aerobic organism. That’s why it’s compatible with living cells, tissues, and sensitive biological specimens.
Head-to-head: enzymatic vs. chemical oxygen removal
| Characteristic | Oxyrase® (Enzymatic) | Thioglycolate | L-Cysteine | Sodium Sulfide |
|---|---|---|---|---|
| Mechanism | Enzymatic catalysis via ETC | Chemical reduction (-SH) | Chemical reduction (-SH) | Chemical reduction (S²⁻) |
| Catalytic? | ✓ Self-regenerating | ✗ Consumed | ✗ Consumed | ✗ Consumed |
| Byproducts | H₂O only | Disulfide (RSSR) | Cystine (disulfide) | Elemental sulfur, H₂S |
| Reactive intermediates? | ✓ None | ✗ Possible | ✗ Possible | ✗ H₂S, sulfur |
| Continuous scavenging | ✓ With substrate | ✗ Depletes | ✗ Depletes | ✗ Depletes |
| Specificity for O₂ | High | Moderate | Moderate | Low |
Where the enzyme system shows up
It started in anaerobic bacteriology. But anywhere dissolved oxygen causes problems (photobleaching under a microscope, lipid peroxidation during sperm freezing, oxidative browning in wine), the same enzyme technology applies. Over 1,500 peer-reviewed papers have put it to work.
Anaerobic Culture
OxyPRAS Plus and OxyPlates replace jars, chambers, and post-reduction protocols. Labs running side-by-side validations consistently recover Peptostreptococcus, Fusobacterium, and other fastidious anaerobes they weren’t seeing before.
Primary ApplicationFluorescence Microscopy
OxyFluor scavenges dissolved O₂ from imaging buffers, extending fluorophore lifetimes up to 20-fold. Used in single-molecule FRET, TIRF, live-cell, and dSTORM, with no pH drift.
290+ CitationsCryopreservation
Dissolved O₂ during freezing drives lipid peroxidation and membrane damage. Removing it before the freeze-thaw cycle improves post-thaw motility and viability. Published in mouse, primate, stallion, bull, buffalo, and boar models.
Fastest GrowingAntioxidant & Pharma
EC-Oxyrase removes oxygen from diagnostic reagents, drug formulations, and shelf-life-sensitive biologicals. Available as bulk OEM enzyme for integration into third-party products.
OEM AvailableWine & Food Science
Enzymatic O₂ removal prevents oxidative browning and preserves volatile aroma compounds, using lactate already present from malolactic fermentation. The only byproduct is water. No sulfite labeling required.
Sulfite-Free OptionHypoxia & Radiation Research
Need a low-oxygen environment for studying radiosensitivity or bioreductive agents? Oxyrase gets you there in a standard incubator. No glove box, no gas tank, no special chamber.
Research UseYour current media might be leaving anaerobes on the table
Two product lines, same enzyme technology. OxyPlates give you anaerobic incubation without any of the equipment. OxyPRAS Plus gives you PRAS-quality media that stays reduced on the open bench. Both convert O₂ to water enzymatically, which means no toxic oxygen radicals form during sterilization, and no post-reduction wait.
OxyPlates: anaerobic culture in a standard plate
The Oxyrase enzyme is built right into the agar, inside a patented OxyDish with an inner sealing ring. Apply your OxyBlue indicator, streak the specimen, close the lid, and put it in a regular 35°C incubator alongside your aerobic plates. The enzyme scavenges O₂ from the medium and headspace simultaneously. OxyBlue goes from blue to white when conditions are anaerobic. You can open, read, re-seal, and re-incubate without losing anaerobiosis.

OxyPRAS Plus: PRAS media without the 24-hour wait
These plates ship pre-reduced. No 12–24 hour reduction step before you can use them. And because the enzyme keeps working, they hold their reduced state for up to two hours in ambient air once you pull them from the sleeve. Competing pre-reduced plates start oxidizing within 15–20 minutes. The full formulation menu includes Brucella Blood Agar, KVL, PEA, BBE, and others.
The Gannon/Thurston data (1997): 212 consecutive wound specimens. OxyPlates recovered 39 anaerobic isolates the conventional chamber missed, mostly Peptostreptococcus, Eubacterium, and Propionibacterium. The CDC followed up (Wiggs et al., 2000) with 251 reference strains: 100% equivalent growth for C. perfringens, 90.3% for the B. fragilis group.
There’s a susceptibility testing angle, too. Spangler and Appelbaum showed that Oxyrase-based anaerobic MIC testing avoids the CO₂ confound built into standard anaerobic chambers. Their data on macrolide MICs, azithromycin especially, shifted substantially when CO₂ was removed from the equation.
Keeping fluorophores alive longer
Photobleaching is an oxygen problem. An excited fluorophore’s triplet state reacts with dissolved O₂, generates singlet oxygen, and the dye is destroyed. Pull the oxygen out of the imaging buffer and the pathway shuts down.
OxyFluor (100× concentrate) has been in cell biology labs since the early 1990s. Clare Waterman-Storer used it for her microtubule dynamics work, Rodionov and Borisy ran it at 2% with 20 mM lactic acid for their 1997 treadmilling paper in Science. It became standard kit for anyone doing live-cell fluorescence of cytoskeletal dynamics, mitosis, or cell migration.
In 2016, two groups independently brought it into super-resolution. The OxEA buffer (OxyFluor + lactate + β-mercaptoethylamine) sustains fluorophore blinking for four-plus hours with no pH drift. The standard glucose oxidase/catalase system? It acidifies from pH 8.0 to around 6.0 within an hour and produces H₂O₂ along the way. If you’re imaging live cells, that matters; your buffer is killing what you’re trying to watch. OxyFluor produces water and nothing else.
Why oxygen is the enemy during freezing
When cells go through a freeze-thaw cycle, dissolved oxygen drives reactive oxygen species formation: lipid peroxidation, membrane disruption, premature capacitation in sperm. Get rid of the oxygen before freezing, and the damage pathway is cut off at the source.
Six published studies, six species (mouse, rhesus monkey, stallion, Sahiwal bull, buffalo, Hampshire boar), from 2000 to 2022. The findings are consistent: Oxyrase in the cryopreservation extender improves post-thaw motility, membrane integrity, and acrosomal intactness while reducing malondialdehyde and other peroxidation markers. Three of those six papers came out between 2020 and 2022, this is an active research area.
For microorganism storage, the product lineup includes CryoBroth (glycerol-based, ≤ −80°C), OxyStasis (≤ −20°C, no ultra-low freezer required), and OxyStab (solid agar, room temperature). All three have the enzyme system built in.

What we make
Same core enzyme, different formulations depending on what you’re doing with it. Here’s the lineup.
OxyPlates
Anaerobic culture in a standard plate. Enzyme is in the agar, OxyDish seals the atmosphere, OxyBlue tells you when you’re anaerobic. No jars, no chambers.
OxyPRAS Plus®
PRAS media, pre-reduced and ready to streak. Holds reduced state on the bench for up to 2 hours in open air.
Oxyrase for Broth & Agar
Concentrated enzyme you add to your own media. Pair with OxyDish to build custom OxyPlates in any formulation you need.
OxyFluor™
100× concentrate for imaging buffers. Scavenges dissolved O₂ to prevent photobleaching in live-cell, TIRF, single-molecule, and super-resolution work.
EC-Oxyrase®
Bulk enzyme for removing oxygen from reagents, diagnostics, and biological products. Available as OEM supply for third-party integration.
CryoBroth & OxyStasis™
Cryopreservation media with the enzyme built in. CryoBroth for −80°C storage, OxyStasis for −20°C. No ultra-low freezer required for OxyStasis.
It started with a radiation experiment gone right
In 1981, Howard Adler was studying radiation-injured bacteria at Oak Ridge National Laboratory. He noticed that sterile membrane fragments from certain bacteria were helping irradiated cells recover, and quickly figured out why: the fragments were still pulling oxygen out of the medium.
Try it in your own lab
We’ll send you plates. Run them alongside what you’re using now. That’s the fastest way to see what the enzyme system does for anaerobic recovery, fluorescence signal, or anything else oxygen is degrading in your workflow.